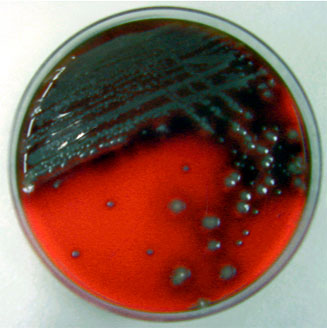

|
La detección
e identificación de S. suis se basa de forma
tradicional en el aislamiento, caracterización bioquímica
y serotipificación; aunque este proceso, si bien sencillo,
puede presentar problemas como son la existencia de cepas
en las que es imposible una caracterización tradicional,
la presencia de bacterias viables pero no cultivables o bien
células muertas (por la aplicación de terapias
antibióticas previas, por ejemplo) o el empleo de medios
de cultivo poco adecuados para el aislamiento de este agente.
A esto hay que añadir la gran variabilidad fenotípica
entre los diversos serotipos, por lo que la identificación
bioquímica tradicional debe ir seguida de una confirmación
por serología.
|
|
Como ocurre en la gran mayoría
de las enfermedades infecciosas, los datos epidemiológicos,
los signos clínicos y las lesiones tan sólo
sirven para un diagnóstico presuntivo, por lo que el
diagnóstico definitivo requiere el aislamiento e identificación
del agente etiológico.
El medio de cultivo que mejores
resultados proporciona para el aislamiento de S. suis
es el medio CNA (Medio de Agar Sangre suplementado con ácido
nalidíxico y sulfato de colistina). Gracias a estos
agentes, se evita el crecimiento de bacterias Gram-negativas
que podrían aparecer por defectos en la toma de muestra,
dificultando la interpretación del crecimiento primario
en la placa de cultivo e incluso impidiendo el aislamiento
del S. suis. Una vez obtenido el cultivo puro, la caracterización
fenotípica se puede realizar con gran rapidez y fiabilidad
mediante el empleo de sistemas multi-substrato RAPID ID 32
STREP (bioMérieux), lográndose la identificación
en tan sólo 4 horas tras haber inoculado la galería.
|
|

Aunque S. suis no es una bacteria fácilmente
transmisible, no debe olvidarse que se trata de un agente
zoonótico, por lo que conviene mantener medidas de
bioseguridad, principalmente al manipular muestras potencialmente
contaminadas.
|
| Muestras a remitir al Laboratorio |
Primoaislamiento en un medio general (Agar-sangre)
de una muestra clínica, donde, además de S.
suis aparece como contaminante una enterobacteria.
|
|

La misma muestra sembrada en medio CNA, donde
se ha impedido el crecimiento de la enterobacteria.
|
|

Reacción típica
de Streptococcus suis en el sistema multi-substrato
Rapid ID32 Strep (bioMérieux).
|
|
Sin embargo, y debido a la existencia de cepas
no cultivables, muchas veces se necesita la identificación
in situ de S. suis. Entre estas técnicas se
pueden destacar la inmunofluorescencia indirecta (IFI), la
peroxidasa-antiperoxidasa (PAP) y la hibridación
in situ.
|
|

Reacción peroxidasa-antiperoxidasa (PAP)
positiva en el seno de un foco inflamatorio.
|
|
Las técnicas inmunohistológicas
poseen la desventaja de que al detectar caracteres fenotípicos
de la bacteria (epitopos) éstos pueden no aparecer
de forma constante en todas las cepas, mientras que esta variación
fenotípica no es un problema cuando la diana utilizada
para el diagnóstico es el rARN, aunque de este modo
no se podría determinar el serotipo de la cepa analizada
y, además, la sensibilidad de la técnica depende
del número de copias de rARN y por lo tanto de la actividad
fisiológica de la bacteria en el momento en el que
se realiza la fijación del tejido, siendo, por otro
lado, la fluorescencia obtenida por este método menos
clara y más difícil de interpretar que la obtenida
mediante IFI. Las muestras analizadas por la técnica
PAP no obligan a la utilización de un microscopio de
fluorescencia y las muestras pueden almacenarse durante mucho
más tiempo, permitiendo, además, la observación
de los procesos inflamatorios asociados al antígeno.
|
|
La identificación serológica
de S. suis se basa en la caracterización del
antígeno polisacarídico de la pared. La serotipificación
de S. suis se realiza principalmente por la técnica
de coaglutinación debido a su rapidez, fiabilidad y
facilidad de interpretación, aunque existen otras que
pueden complementarla. Dentro de las infecciones por S.
suis, en los casos de meningitis la presencia de cepas
no detectables mediante el empleo de anticuerpos (técnicas
IFI/PAP) es similar a la que existe en otros órganos,
aspecto en el que destacan las cepas causantes de endocarditis
valvular crónica, donde las cepas son mayoritariamente
no-capsuladas y por lo tanto imposibles de serotipificar.
Existen reacciones cruzadas entre varios serotipos debido
a que poseen determinantes antigénicos comunes. Así,
se han descrito reacciones cruzadas entre los serotipos 1
y ½ al emplear IFI o PAP como método diagnóstico.
|
|
Se ha tratado de realizar el diagnóstico
serológico mediante la técnica ELISA ("Enzyme
Linked Immunosorbent Assay"), aunque no se encontraron
diferencias en los títulos de anticuerpos entre los
animales infectados y no infectados, por lo que hasta el momento,
la técnica carece de utilidad diagnóstica. Esta
técnica tampoco sirvió para detectar S. suis
en tejidos ni para diferenciar los serotipos ½ y 2.
|
Imprimir
|